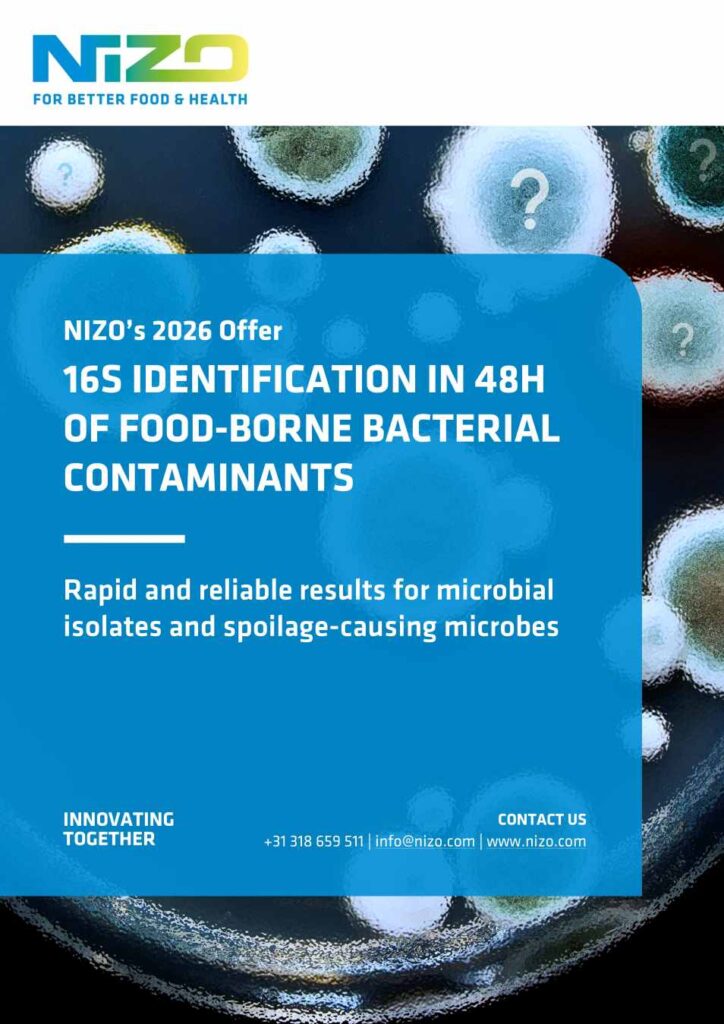
NIZO_2026_16sIdentification_Leaflet_P1_rs

When it comes to bacterial contamination in your food product, time is crucial! You need not only a fast assessment to take decisions, but also full insights into it:
- Is it still possible to release the product?
- Is this a “one-off” event, or an ongoing issue that needs to be addressed?
- What is the ‘bug’ in your sample?
- What is its pathogenicity status? Its sources?
- How to prevent it? Can the contaminant produce spores that are heat resistant?
- Can we identify the microbe if it is unculturable or already dead?…
All these questions will be answered by NIZO’s limited offer: 16s identification in 48h of food-borne bacterial contaminants – Rapid and reliable results for microbial isolates and spoilage-causing microbes.
Get to the bottom of your potential bacterial contamination – quickly, efficiently and reliably with NIZO!
Please fill in this form to download the leaflet.
"*" indicates required fields